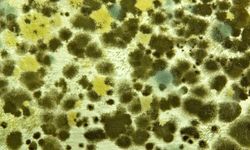
Sonbaharda alerjilere dikkat: Polenler gitti, küf mantarları geldi

The Hill gazetesinde yer alan habere göre, Teksas Üniversitesi Sağlık Bilimleri Merkezince yürütülen araştırma, hamilelik ve emzirme döneminde günde en az bir diyet içecek veya eş değer miktarda yapay tatlandırıcı tüketimi ile erkek çocuklarda otizm görülmesi arasında bağ olduğunu ortaya koydu. Araştırma kapsamında, otizm spektrum bozukluğu olan 235 ve bu gelişim bozukluğuna sahip olamayan 131 çocuğun ebeveynlerine hamilelik ve emzirme dönemindeki diyet içecek ve yapay tatlandırıcı tüketim sıklığı incelendi. Annelere hamilelik ve emzirme döneminde diyet kola ve yapay tatlandırıcı içeren içecekleri hangi sıklıkla tükettikleri soruldu.
MUHTEMEL KANSEROJEN
Araştırma sonuçları, otizm spektrum bozukluğuna sahip erkek çocuklarının, hamilelik döneminde diyet içecek tüketen bir anneye sahip olma ihtimalinin normal erkek çocuklara göre 3 kat daha fazla olduğunu gösterdi. Yapay tatlandırıcı olarak kullanılan "aspartam" ile otizm arasındaki bağlantının ortaya konması adına daha büyük örneklem grubu ile yeni araştırmalar yapılması gerektiği aktarıldı. Dünya Sağlık Örgütü (DSÖ), Haziran ayında yapay tatlandırıcılardan aspartamı, insanlar için "muhtemel kanserojen" olarak sınıflandırmış, günlük alım miktarı aşılmadığı sürece kullanımının güvenli olduğunu açıklamıştı. Araştırma kapsamında, kız çocuklarına ilişkin istatistiksel olarak anlamlı bir ilişki bulanmadığı belirtildi. Araştırmanın sonuçları, "Nutrients" dergisinde yayımlandı.